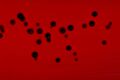
تصغير للنسخة بتاريخ 00:04، 4 ديسمبر 2023
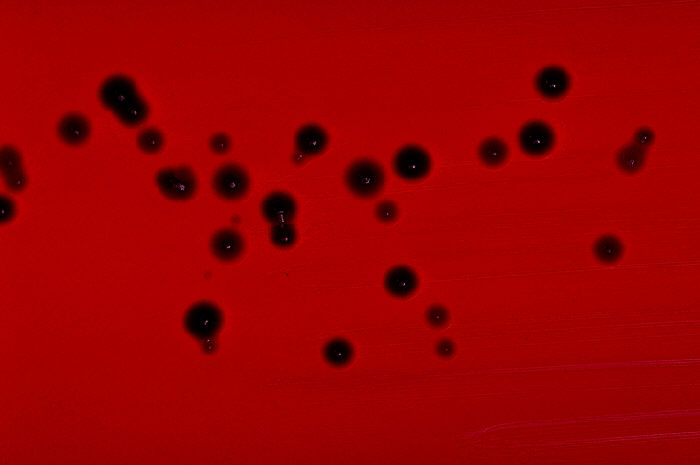

ملف:Chromobacterium violaceum blood agar.jpg
Chromobacterium_violaceum_blood_agar.jpg (700 × 465 بكسل حجم الملف: 23 كيلوبايت، نوع MIME: image/jpeg)
| Description | Blood agar plate culture of Chromobacterium violaceum. |
| Date | 1977 |
| Source | قالب:CDC-PHIL |
| Author | CDC/ Dr. W.A. Clark |
| ⧼wm-license-information-permission⧽ (⧼wm-license-information-permission-reusing-text⧽) |
قالب:PD-USGov-HHS-CDC |
تاريخ الملف
اضغط على زمن/تاريخ لرؤية الملف كما بدا في هذا الزمن.
| زمن/تاريخ | صورة مصغرة | الأبعاد | مستخدم | تعليق | |
|---|---|---|---|---|---|
| حالي | ★ مراجعة معتمدة 00:04، 4 ديسمبر 2023 | | 700 × 465 (23 كيلوبايت) | Pastakhov (نقاش | مساهمات) | Upload https://upload.wikimedia.org/wikipedia/commons/6/63/Chromobacterium_violaceum_blood_agar.jpg |
لا يمكنك استبدال هذا الملف.
وصلات
لا يوجد صفحات تصل لهذه الصورة.